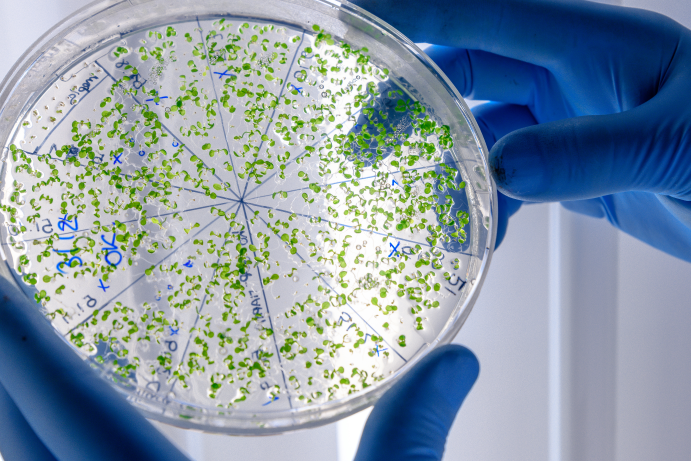

Свинячий ціп’як – вид глистів, яким може заразитися будь-який любитель м’яса.
Свинячий ціп’як шляху зараження
Свинячий ціп’як як проміжні господарі використовує собак, кроликів, свиней. Але остаточним господарем виступає лише людина. Це паразитарне захворювання називається теніозом. Хвороба дуже небезпечна і викликає безліч ускладнень, тому лікування свинячого ціп’яка обов’язкове. І чим раніше, тим краще.
Паразит досягає розмірів до 2-3 м із чотирма присосками на голові. За рахунок цього він міцно чіпляється всередині кишківника людини.
Заразитися ним можна через вживання погано приготовленого свинячого м’яса. Вже хворий може заражати решту людей личинками.
Симптоми теніозу, свинячого ціп’яка
- Нудота
- Блювота
- Втрата ваги
- Відсутність апетиту
- Біль в животі
- Сверблячка анального отвору
- Головні болі
- Нестача заліза

Але варто врахувати, якщо свинячий ціп’як вражає головний мозок, то у хворого може спостерігатися запаморочення, порушення мови, галюцинації та психічні відхилення.
Якщо паразит у вічі, то з’являються почервоніння очного яблука, які часто плутають з кон’юнктивітом.
Діагностика свинячого ціп’яка
Свинячий ціп’як, або трихінельоз, є хворобою, яку спричинюють нематоди роду Trichinella. Ці паразити можуть заражати свиней та інших тварин, а також людей.
Для діагностики свинячого ціп’яка використовують різні методи, зокрема:
- Серологічні тести: Визначення наявності антитіл до Trichinella в крові може бути проведено за допомогою різних тестів, таких як імунодифузія, імуноблоттинг чи ензимоімунноаналіз.
- Біопсія м’язів: Вибірка тканини з м’язів, зазвичай з м’язу діафрагми, може бути піддана лабораторному дослідженню для виявлення кіст Trichinella.
- Полімеразна ланцюгова реакція (ПЛР): Дослідження ДНК паразита може бути проведено за допомогою ПЛР для визначення наявності Trichinella у біологічних зразках.
- Клінічні симптоми: Врахування клінічних симптомів, таких як м’язовий біль, набряклість обличчя, головний біль і лихоманка, може допомогти у підозрі на трихінельоз.
- Також у нашій клініці можна аналіз стану всього організму із застосуванням системи Комплекс Медичний Експертний
Методи лікування свинячого ціп’яка
Лікування свинячого ціп’яка, як і власоголов, гострики та інших глистових захворювань за допомогою протипаразитарної програми у Києві в Медичному центрі «Альтернатива». Це два послідовні курси по 5 днів з програмою, що очищає. Так за цей час очищається печінка, кров, судини, кишківник, лімфа та інші органи від токсинів, глистяних інвазій, бактерій та грибків.
Також використовується лікування за допомогою ректальних інсуфляцій, мікроклізми з озонованою оливковою олією та прийому озонованої води. Якщо необхідно, як домашнє лікування призначається лікувальна дієта, ректальні свічки або гомеопатія.
Переваги діагностики та лікування Свиного ціп’яка в МЦ Альтернатива
- Все лікування проводиться без токсичних ліків
- Очищується весь організм, що сприяє нормальному функціонуванню всіх органів
- Підвищується імунітет
- Програма розроблена окремо для дорослих та дітей
- Є можливість вибору стаціонарного чи амбулаторного лікування